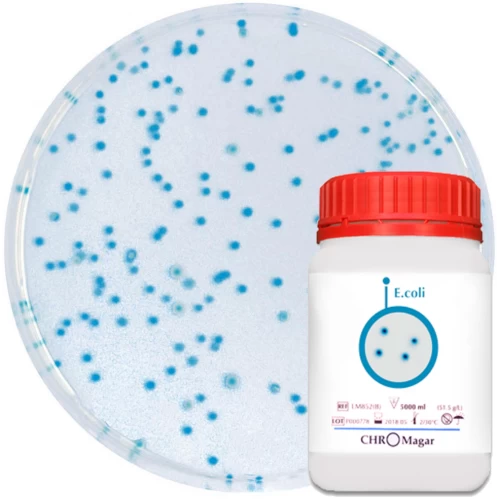
Хромогенне середовище для виявлення та підрахунку E. coli / CHROMagar™ E.coli

24930000-2 Фотохімікати
Назва категорії: Живильні середовищаОдиниці виміру: штука
Технічні характеристики
Вид
Відповідність ДСТУ EN ISO 11133:2014
Фасування
Основа складу
Знайдено: 253

Поживний агар Sanimed-M

Основа уреазного агару за Крістенсеном / CHRISTENSEN UREA AGAR BASE, Sanimed-M

Агар Мюллера-Хінтона II / MUELLER HINTON II AGAR згідно з EUCAST, Sanimed-M
Хромогенне середовище для виявлення та підрахунку E. coli / CHROMagar™ E.coli

Біфідум середовище / BIFIDUM MEDIUM, Sanimed-M

Агар Ендо Sanimed-M

Нітратний бульйон / NITRATE BROTH, Sanimed-M

Основа агара Берд-Паркера / BAIRD PARKER AGAR BASE, 250 г

Основа середовища Хойла / HOYLE MEDIUM BASE, Sanimed-M

Менінгоагар / MENINGOAGAR, Sanimed-M

Sanimed -m CHROM Orientation
